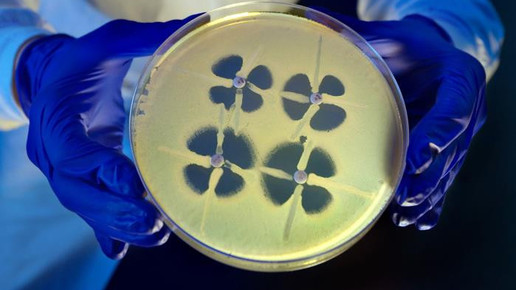
Carbapenem Resistant Enterobacteriaceae cdc melissa dankel
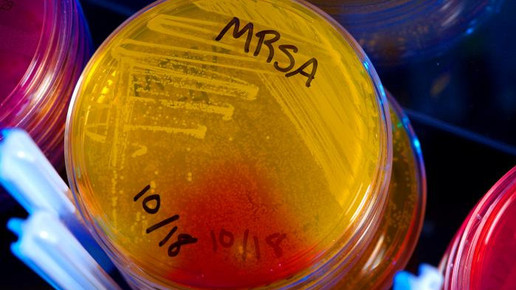
Staphylococcus aureus MRSA cdc james gathany

Pneumokokken-Impfung verhindert Lungenentzündung
Bakterien können eine Lungenentzündung auslösen, die tödlich verlaufen kann. Aber nur 30 Prozent der Senioren zwischen 65 und 79 Jahren sind gegen Pneumokokken geimpft. Die Barmer rät daher, vor dem Start der nasskalten Jahreszeit auf einen ausreichenden Impfschutz zu achten.
„80 Prozent der Lungenentzündungen gehen auf Bakterien zurück, gegen die man sich gut schützen kann. Gerade für ältere Menschen ist daher eine Impfung gegen Pneumokokken sinnvoll“, rät Dr. Ursula Marschall, leitende Medizinerin bei der Barmer. Jährlich erkranken etwa 800.000 Menschen in Deutschland an einer Lungenentzündung, die sie sich nicht im Krankenhaus zugezogen haben.
„Die Lungenentzündung gehört klar zu den Volkskrankheiten. Jedes Jahr werden mit dieser Diagnose mehr Menschen ins Krankenhaus eingeliefert als nach einem Herzinfarkt oder Schlaganfall. Zehn Prozent der Betroffenen müssen sogar auf der Intensivstation behandelt werden. Sie ist die häufigste zum Tode führende Infektionskrankheit“, erklärt Marschall. Betroffen sind vor allem Personen mit einem geschwächten Immunsystem, wozu nicht nur viele ältere Menschen, sondern auch Kinder gehören. Zudem begünstigen Risikofaktoren wie Rauchen, Diabetes Mellitus oder neurologische Erkrankungen die Entstehung einer Lungenentzündung.
Typische Symptome für eine Lungenentzündung sind schnell ansteigendes Fieber, Schüttelfrost und Husten, aber auch ein allgemeines Schwächegefühl und Atembeschwerden. Eine Lungenentzündung kann aber auch komplett atypisch verlaufen, was die Diagnosestellung manchmal etwas erschwert. Ältere Menschen können verwirrt sein, oder sie befinden sich in einer Art Dämmerzustand. Und auch der Anstieg des Fiebers muss nicht immer so drastisch sein. „Eine rasche Diagnosestellung ist bei der Lungenentzündung wichtig, um vor allem bei Personen mit einem geschwächten Immunsystem ein Verschleppen zu verhindern. Im Zweifel kann eine Röntgenaufnahme Klarheit bringen“, sagt Marschall.

APOTHEKE ADHOC Debatte